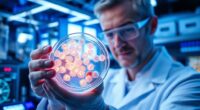
senolytics slow aging

Understanding your menstrual cycle involves recognizing its different phases and hormonal shifts. It begins with menstruation, when your uterine lining sheds due to low estrogen and progesterone levels. Then, in the follicular phase, FSH stimulates follicle growth, and estrogen rebuilds the lining. During ovulation around day 14, a surge in LH triggers egg release. In the luteal phase, progesterone prepares your uterus for possible pregnancy. Exploring these changes can help you better understand your body’s natural rhythms, leading to more awareness of your fertility and health.
Key Takeaways
- The menstrual cycle consists of phases: menstrual, follicular, ovulation, and luteal, each with distinct hormonal changes.
- Estrogen levels rise during the follicular phase, leading to uterine lining rebuilding and ovulation.
- A surge in luteinizing hormone (LH) triggers ovulation around day 14.
- Progesterone peaks during the luteal phase to maintain the uterine lining for potential pregnancy.
- Hormonal fluctuations throughout the cycle regulate physical and emotional changes and fertility signs.

Understanding the menstrual cycle is essential because it influences many aspects of your health and well-being. As you go through each phase, your body experiences a series of hormonal fluctuations that regulate everything from fertility to mood. Recognizing how these changes occur can help you better understand your body’s signals and manage your health more effectively.
The cycle begins with the menstrual phase, when your uterus sheds its lining, resulting in bleeding. During this time, hormone levels like estrogen and progesterone are at their lowest, prompting the start of your cycle. As bleeding subsides, your body shifts into the follicular phase. Here, the pituitary gland releases follicle-stimulating hormone (FSH), which stimulates the growth of ovarian follicles. Each follicle contains an immature egg, and as they develop, estrogen levels rise. This increase in estrogen helps rebuild the uterine lining, preparing it for potential pregnancy.
One of the most vital aspects of this phase is ovulation timing. Typically occurring around the midpoint of your cycle, ovulation is triggered when a surge of luteinizing hormone (LH) causes the mature follicle to release an egg. This release marks the peak fertility window of your cycle. The hormonal fluctuations during ovulation not only influence the release of the egg but also cause physical signs like a rise in basal body temperature or changes in cervical mucus. Recognizing these signs can help you determine your most fertile days, whether you’re trying to conceive or simply want to understand your body’s rhythm better.
Following ovulation, your body enters the luteal phase. The ruptured follicle transforms into the corpus luteum, which secretes progesterone. This hormone maintains the thickened uterine lining, readying it for a possible pregnancy. If fertilization doesn’t occur, the corpus luteum degenerates, leading to a drop in progesterone and estrogen. This hormonal decline triggers the shedding of the uterine lining, and the cycle begins anew with menstruation. During this phase, you might notice symptoms like breast tenderness or mood swings, which are also linked to hormonal fluctuations.
Throughout the cycle, these hormonal shifts—particularly fluctuations in estrogen, progesterone, and LH—drive the physical and emotional changes you experience. Being aware of these patterns, especially ovulation timing, can empower you to better understand your body’s natural rhythms. Whether you’re tracking fertility, managing symptoms, or just seeking to know more about yourself, understanding these phases and their hormonal dynamics helps you stay in tune with your health.
menstrual cycle tracking app
As an affiliate, we earn on qualifying purchases.
As an affiliate, we earn on qualifying purchases.
Frequently Asked Questions
How Does Stress Affect the Menstrual Cycle?
Stress can considerably affect your menstrual cycle by disrupting hormonal balance. When you don’t manage stress well, it impacts hormonal impact, potentially causing irregular periods, missed cycles, or heavier bleeding. To keep your cycle regular, prioritize stress management techniques like exercise, meditation, or adequate sleep. Reducing stress helps your hormones stay balanced, supporting a healthier cycle and overall well-being.
Can Exercise Influence Hormonal Fluctuations During the Cycle?
Exercise impact can markedly influence hormonal fluctuations during your cycle. Regular physical activity helps regulate hormones like estrogen and progesterone, potentially easing symptoms and balancing cycles. However, intense or excessive exercise might disrupt hormonal levels, causing irregularities or missed periods. You should aim for moderate exercise to support hormonal balance, as it promotes overall reproductive health and can reduce cycle-related discomfort.
Are There Natural Remedies to Regulate Irregular Periods?
Think of your body as a garden that needs nurturing. You can help regulate irregular periods naturally with herbal supplements like ginger or raspberry leaf tea, and by making dietary adjustments such as reducing processed foods and increasing fruits and vegetables. These simple, holistic approaches can support hormonal balance and promote regularity, helping your cycle flourish like a well-tended garden.
What Are the Early Signs of Hormonal Imbalance?
You might notice symptoms like irregular periods, severe PMS, unexplained weight changes, or mood swings, which indicate hormonal fluctuation. Being aware of these symptoms helps you recognize early signs of imbalance. Pay attention to persistent fatigue, acne, or changes in sleep patterns, as they also signal hormonal shifts. Staying symptom-aware allows you to consult a healthcare provider promptly to address potential hormonal imbalance before it worsens.
How Does Age Impact Menstrual Cycle Length and Regularity?
As you age, think of your cycle as a river shifting its course—age-related changes can cause your cycle length and regularity to fluctuate. In your 30s and 40s, hormonal fluctuations bring increased cycle variability, much like unpredictable currents. Eventually, in your 50s, menopause marks the river’s quiet end. Recognizing these changes helps you understand and manage your cycle better through life’s natural ebb and flow.
fertility monitor basal body thermometer
As an affiliate, we earn on qualifying purchases.
As an affiliate, we earn on qualifying purchases.
Conclusion
Understanding the menstrual cycle helps you better appreciate your body’s natural rhythm. By recognizing the different phases and hormonal shifts, you can tune into what’s happening inside you. Isn’t it empowering to know your body’s signs and changes? Embrace this knowledge to feel more in control and connected to your health. Remember, every cycle is a reminder of your resilience and strength—so listen to your body and honor its unique journey.
menstrual pain relief heating pad
As an affiliate, we earn on qualifying purchases.
As an affiliate, we earn on qualifying purchases.
cervical mucus test kit
As an affiliate, we earn on qualifying purchases.
As an affiliate, we earn on qualifying purchases.